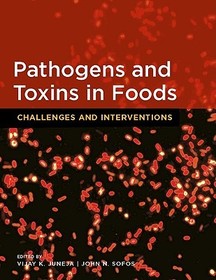
Pathogens and Toxins in Food: Challenges and Interventions

Találatok 12

Handbook of Industrial Thermal Processing of Food
50 641 Ft
45 577 Ft

Omics, Microbial Modeling and Technologies for Foodborne Pathogens
65 115 Ft
59 906 Ft

Advances in Microbial Food Safety
63 301 Ft
56 971 Ft